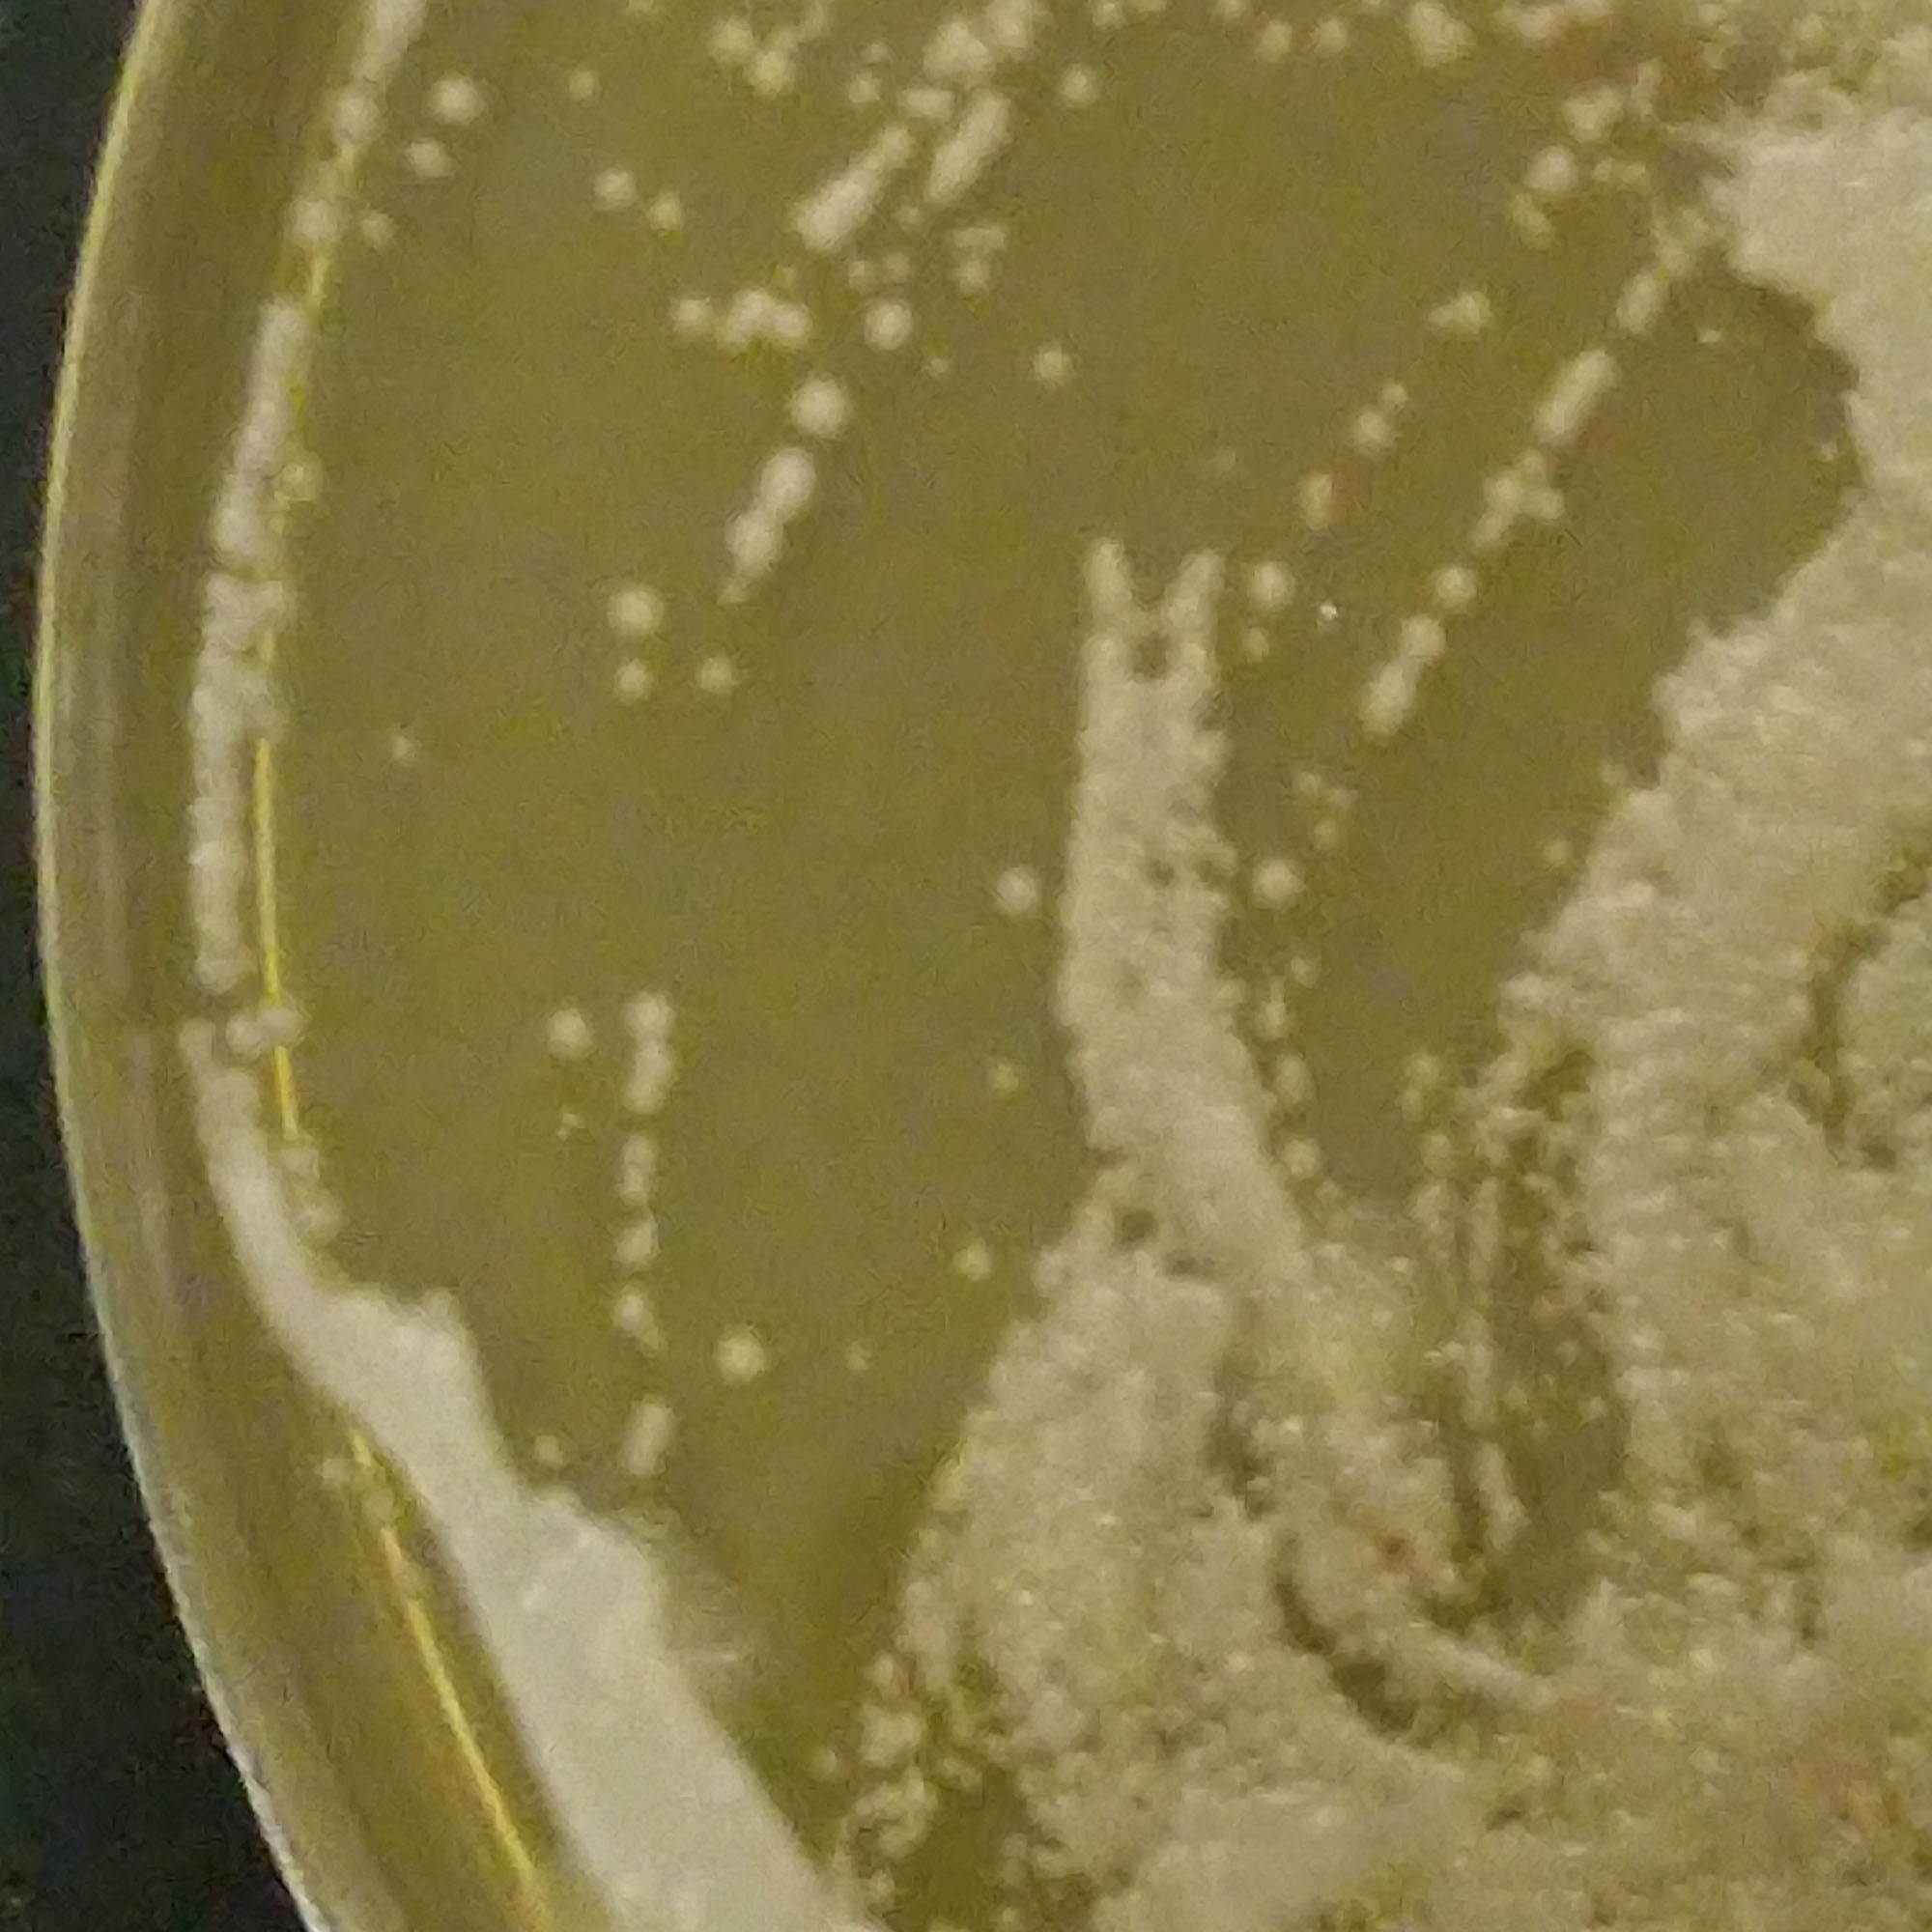

Tko je jači – kvasac ili modra galica?
1. Promatrajmo u prirodi
- korištenje pekarskog kvasca u kućanstvu za pripremu tijesta
- kuhanje kokošjeg jaja
- pojava plijesni na hrani
2. Prisjetimo se što već znamo o uočenoj pojavi /procesu
- carstvo gljiva, jednostavne gljive i plijesni
- jednostanične gljive – kvasci
- uzgoj mikroorganizama na hranjivoj podlozi u Petrijevoj zdjelici
- koagulacija bjelančevina
- utjecaj kiselina, lužina i soli na koagulaciju bjelančevina
3. Postavimo istraživačka pitanja
- Utječe li koncentracija otopine modre galice na koagulaciju bjelančevina stanice kvasca?
- Razvijaju li stanice kvasca otpornost na prisustvo otopine modre galice?
4. Oblikujmo pretpostavku
- Otopina modre galice djeluje štetno na stanicu kvasca – izaziva koagulaciju njenih bjelančevina.
- Otopina modre galice veće masene koncentracije uništava veći broj stanica kvasca.
5. planirajmo i provedimo istraživanje
1. Priprema suspenzije svježeg kvasca
- Pripremite jednu šalicu (2 dL) tople vode (temp. oko 30 °C), dodajte žlicu šećera i smrvljenu jednu kocku svježeg pekarskog kvasca.
- Sve promiješajte žličicom i ostavite na toplom mjestu kroz desetak minuta.
- Kad se suspenzija kvasca zapjeni kapaljkom odvojite 1 mL suspenzije.
- Pripremite deset epruveta na stalku i za njih odgovarajuće gumene čepove.
- U svaku epruvetu stavite 10 mL destilirane vode i jednu kap suspenzije kvasca.
- Začepite gumenim čepom i primiješajte sadržaj epruvete.
- Svaku epruvetu označite oznakom skupine A (kontrolna skupina).
2. Priprema hranjive podloge
- U manju Erlenmayerovu tikvicu stavite 100 mL destilirane vode,
1 g mesnog ekstrakta (ili ekstrakt kvasca), 2 g glukoze,
2 g peptona i 2 g agara. - Promiješajte, začepite tikvicu sa čepom od vate, stavite tikvicu u pretis lonac i kuhajte do vrenja. Nakon kuhanja pustite smjesu da se na pola ohladi.
- Pripremite za svaku skupinu uzorka deset čistih Petrijevih zdjelica.
- U svaku Petrijevu zdjelicu nalijte skuhane hranjive podloge toliko da pokrije dno posude i odmah zdjelicu poklopite njezinim poklopcem.
- Ostavite Petrijeve zdjelice da se ohlade, a hranjiva podloga stvrdne.
- Svaku Petrijevu zdjelicu označite flomasterom.
3. Priprema otopina modre galice određenih masenih koncentracija
- Pripremite dvije otopine modre galice različitih masenih koncentracija prema svojem odabiru. Primjerice, jedna otopina neka bude sasvim blaga (npr. skupina B), a druga neka bude dvostruko veće masene koncentracije (npr. skupina C).
Napomena: Topljivost modre galice pri 20 °C je 317 g u 1 L vode.
4. Tretiranje suspenzije kvasca otopinom modre galice
- Vratimo se kod deset epruveta skupine A u kojima se nalazi suspenzija kvasca.
- Pripremite još deset novih epruveta i označite ih oznakom skupine B.
- U svaku od epruveta čistom kapaljkom stavite 1 mL otopine modre galice određene masene koncentracije.
- Iz jedne epruvete skupine A čistom kapaljkom prenesite 5 mL suspenzije kvasca u epruvetu skupine B.
- Začepite gumenim čepom i promućkajte. Istu radnju ponovite s preostalih devet epruveta.
- Odlučite koliko vremena će se suspenzija kvasca tretirati otopinom modre galice prije nego je prenesete na hranjivu podlogu u Petrijevoj zdjelici.
5. Nacjepljivanje hranjivih podloga suspenzijom kvasca
- Pripremite Petrijeve zdjelice sa čvrstom hranjivom podlogom.
- U prvih deset Petrijevih zdjelica stavite čistom kapaljkom po 1 mL sadržaja epruveta iz skupine A.
- Iz svake eperuvete ide po 1 mL u posebnu Petrijevu zdjelicu. Ovo će biti kontrolna skupina.
- Označite Petrijeve zdjelice.
- U deset drugih Petrijevih zdjelica ulijte po 1 mL suspenzije kvasca koja je tretirana modrom galicom (skupina B). Isto tako napravite sa uzorkom iz skupine C.
6. Brojanje razvijenih kolonija kvasca u Petrijevoj zdjelici
- Petrijeve zdjelice sa nacijepljenim uzorcima suspenzije kvasca ostavite na toplom i mirnom mjestu u sobi.
- Promatrajte uzorke kroz sedam dana.
- Kad se na hranjivoj podlozi razvije kolonija kvaščevih stanica u obliku bijelih točkica koje možete brojiti, izbrojite razvijene kolonije u svim zdjelicama.
- Zabilježite rezultate – fotografirajte svaki uzorak i slike priložite u dnevnik rada.
6. Analizirajmo rezultate i donesimo zaključke
- Usporedite uzorke prema različitim uvjetima kojima su izloženi.
7. Naša pretpostavka je potvrđena / naša pretpostavka je opovrgnuta
Ako je vaša pretpostavka opovrgnuta, razmislite i pokušajte s novom pretpostavkom.
8. Napravimo izvještaj
Rezultate svojega rada prikažite plakatom ili prezentacijom u Wordu PowerPointu ili Haiku Decku.
Natrag na jedinicu